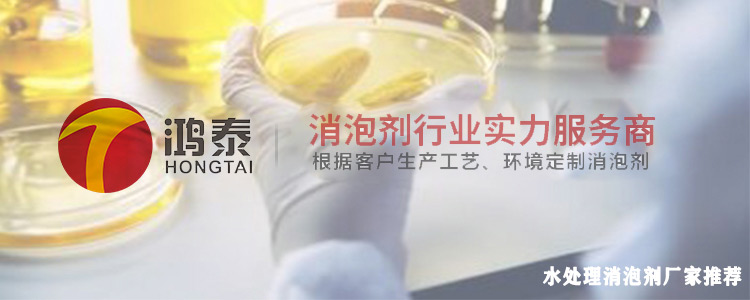

-
1000+ 解决方案应用工艺
-
针对 8000+ 行业专用消泡剂
-
自主消泡剂研发基地 2000m²
-
专属定制消泡解决方案,只需 24小时
自改革开放以来,我国工业一直蓬勃发展着,产生的污水废水也在逐渐增加。后来,国家推出了多项涉及污水处理的政策,作为致力于推进水资源的循环利用的水处理行业,也在悄悄发生着改变。从原本的废水处理市场存在一定区域性,到跨区域竞争发展;从就近选择水处理相关设备与采购药剂(如水处理消泡剂),到尝试选用国内外产品,推动各行业厂家创新进步,大大提升了行业的整体水平。
就从水处理消泡剂厂家来探讨,我们可以发现国内已出现了许多规模较大、经营较早、技术成熟,值得信赖的水处理消泡剂生产企业与厂家,像鸿泰、中联邦、德丰、南辉、高田、粤万、国中(排名不分先后)等品牌,都立足水处理消泡剂行业多年,具有相当丰富的水处理消泡经验。本期水处理消泡剂主题研究报告将为大家讲解水处理消泡剂厂家哪家好,让你在水处理时更安心。
(水处理消泡剂厂家推荐)
一、国内较大消泡剂生产企业
前面我们已经提及的鸿泰消泡剂、中联邦消泡剂、德丰消泡剂、高田消泡剂、粤万消泡剂等多家生产企业厂家,除根据水处理行业起泡特点有研究生产性能优良的水处理消泡剂外,其他涉及的消泡领域也较为广阔。消泡剂种类涵盖有机硅消泡剂、聚醚消泡剂、矿物油消泡剂、非硅消泡剂、磷酸三丁酯消泡剂、改性硅聚醚消泡剂等。对于哪家产品效果、服务质量好,相信尝试选择、运用过的人都有自己的理想答案。
二、水处理消泡剂厂家排名
水处理剂是精细化工产品中的一个重要门类,具有很强的专用性。水处理消泡剂更是作为其重要的助剂,协调水处理过程的顺利进行。能更好地发挥水处理消泡剂的功效,就需要水处理消泡剂厂家的不懈努力与创新。想了解哪家水处理消泡剂厂家好,我们也可以从水处理消泡剂厂家的排名观察一二:
1. 广州市鸿泰新材料有限公司(排名前十,位置靠前)
2. 东莞市德丰消泡剂有限公司(排名前十,位置靠前)
3. 广东中联邦精细化工有限公司(排名前十,位置靠前)
三、水处理消泡剂厂家详细介绍与推荐
本篇为大家介绍的水处理消泡剂厂家是广州市鸿泰新材料有限公司,这是一家在水处理行业内被高度认可的、已成功发展为一家集研发生产、销售服务于一身的大型企业,具有以下四大核心优势。
(鸿泰消泡剂厂家四大优势示意图)
为了保障优良的产品和服务质量以及公司员工的满意度幸福感,鸿泰还秉承多种核心价值观,这些核心价值观也是能被推荐为值得信赖的消泡剂厂家的原因之一了。它们分别是:
1. 理念,精益求精、永无止境,鸿泰消泡剂厂家会不断创新与改进;
2. 方向,创造持续价值,鸿泰消泡剂厂家对于所从事的消泡剂(内含消抑泡能力强的水处理消泡剂)事业,会创造持续长久地价值;
3. 工作方式,鸿泰消泡剂厂家尊重不同观点,在全球范围内交流思想和共同目标;
4. 行事方式,鸿泰消泡剂厂家努力实现目标,言出必行,只为做得更好。
本篇水处理消泡剂厂家的讲解就到这里啦,希望能够对你有所帮助。鸿泰消泡剂厂家专为各行业解决泡沫难题,无论关于水处理、还是其他类型的消泡需求,都能使消泡更快、效率更高、品质更好。水处理消泡剂主题研究报告到这也先告一段落,期待与您再次相遇。





版权所有 © 2021-2041 鸿泰保留一切权利